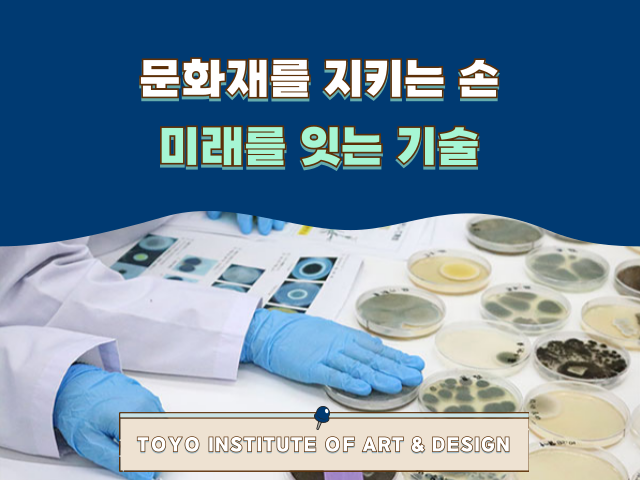

동양미술학교 |
교실을 넘어 갤러리로 동양미술학교 회화과 전시 수업
작성일 2025-12-26
본문
일본에서 미술을 배우고 싶다고 생각할 때
그림을 그리는 기술만큼 중요한 것이 있어요.
바로 내 작품이 누군가에게 닿는
장소에 서는 경험이에요.
학생에게 전시회란,
자신의 그림이 '교실 안'에서 '사회 속'으로
한 걸음 나가는 순간이에요.
이번에는 긴자 아카네 화랑에서 열린
동양미술학교 회화과 학생들의
전시회를 소개합니다,
전시가 열린 곳은 긴자 아카네 화랑이에요.
오랜 시간 프로 작가들의
발표가 이어져 온 역사 있는 갤러리에요.
전시 제목은 '여명(아케보노/曙)'에는
새벽, 즉 새로운 창작의 출발선이라는
의미가 담겨 있어요.
전시장에는 유화, 아크릴, 일본화, 수채화 등
기법도 주제도 서로 다른 작품들이
나란히 걸렸어요.
한 장의 그림을 대하는 태도,
색과 구성을 바라보는 시선은
학생마다 전혀 달라요.
그 차이 자체가 관람객에게는
작품을 통해 '그 사람다움'을 느낄 수 있는 지점이 돼요.
이번 갤러리 전시는
작품을 단순히 '제작하는 것'에서
'발표하는 단계'로 끌어올리는 중요한 경험이 되었어요.
회화과에서는
1학년 때 데생, 색채, 구성, 화재 연구 등
회화 표현의 기초를 탄탄하게 다져요.
2학년이 되면
유화, 아크릴, 일본화 등
자신이 선택한 기법을 중심으로
제작과 크리틱을 반복하며 수업이 진행돼요.
이를 통해 작품을 말로 설명하는 힘,
타인의 시선을 받아들여
작품을 발전시키는 힘을 기르게 돼요.
또한 갤러리 전시회 작품 발표 기회가 많아
그리고 보여주고 피드백을 받는 과정을 통해
표현이 사회로 전달되는 감각을
실제로 체험하며 익힐 수 있어요.
유학생에게는 일본어로 작품 설명과
강평을 주고받는 과정을 통해
작품과 언어, 두 가지 모두로 전달하는 힘을
기를 수 있다는 점도 큰 특징이에요.
졸업 후에는 작가 활동뿐만 아니라
광고, 디자인, 일러스트레이션,
아트 기획, 갤러리 운영 등
표현을 살릴 수 있는 다양한 분야로 진출할 수 있어요.
미술을 배운 경험을
사회에서 어떻게 활용할 것인지에 대한
진로 지원도 충실히 마련되어 있어요.
이번 학생 전시회는
학생들이 자신의 표현을 외부로 향해
발신하는 중요한 단계였어요.
작품 제작을 통해 기술뿐 아니라
자신의 생각을 상대에게 전하려는 태도도
함께 성장해 가요.
일본에서 미술을 배우고 싶다.
자신의 표현을 깊이 있게 다듬고,
발신하는 힘을 기르고 싶다고 생각한다면
동양미술학교의 오픈캠퍼스에 참가해 보세요.
학교에서 만들어진 작품을 직접 보고,
그 공간의 공기를 느껴보는 것부터 시작해 보세요!
오픈캠퍼스를 참여하세요!
https://www.to-bi.ac.jp/dept/cdc/
학교를 체험할 수 있는 기회,
매달 원하는 일정을 선택하여
무료로 수업을 참여할 수 있어요.
(참가에는 예약이 필요합니다)
2026년도 입시 유학생 모집 중!
https://blog.naver.com/u_hakseang/223959793817